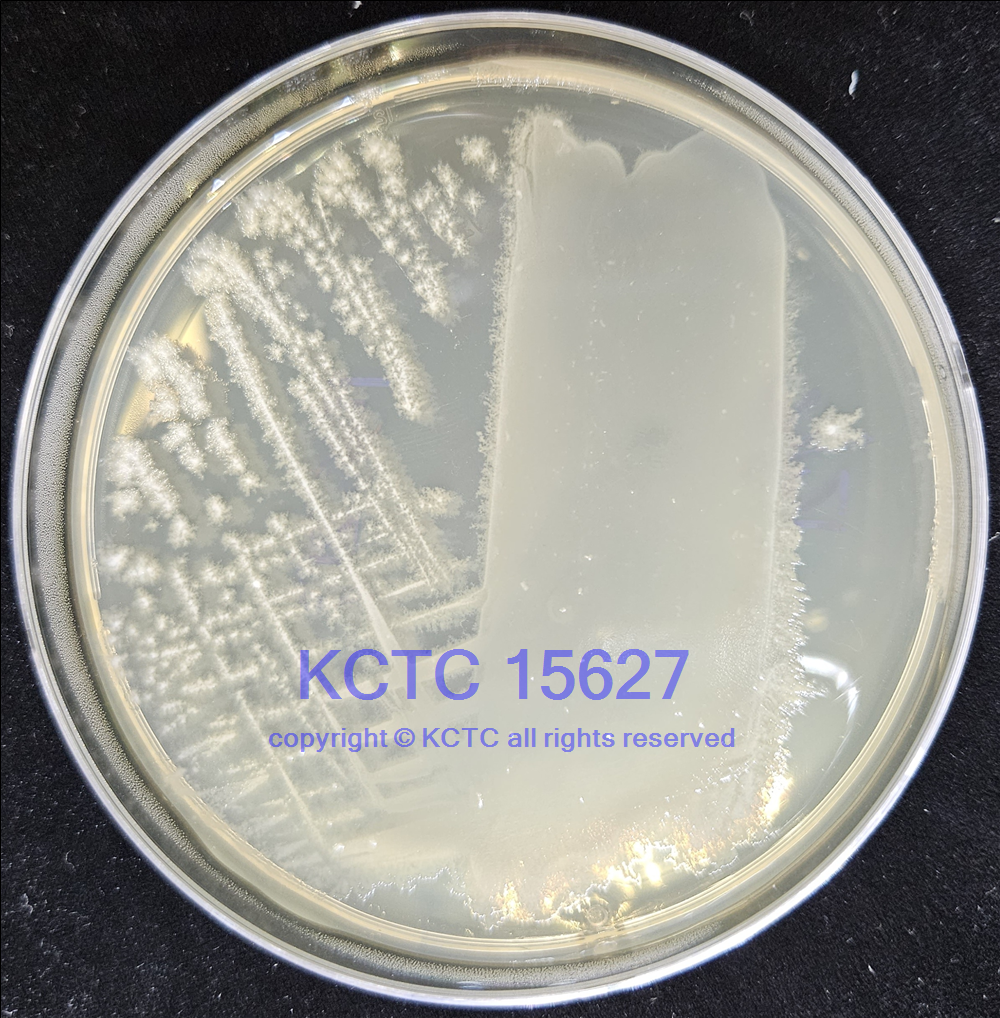

中文名稱:生孢梭菌(產(chǎn)芽孢梭狀芽孢桿菌)
拉丁名稱:Clostridium sporogenes
來源歷史:<--ATCC
收藏時(shí)間:2020-09-16 00:00:00.0
原始編號(hào):L.S. McClung 2006
原產(chǎn)國:美國
模式菌株: 否
主要用途:培養(yǎng)基測(cè)試 質(zhì)量控制 無菌檢驗(yàn) 藥物及個(gè)人護(hù)理用品檢驗(yàn)
生物安全級(jí)別: 一級(jí)
其它保藏中心編號(hào):ATCC 11437
McClung 2006, ATCC [11437], DSM [1446], KCTC [15509], NBIMCC [3542], NBRC [14293], NCIB [12343] KCTC 15627
培養(yǎng)基編號(hào): 54
培養(yǎng)溫度:37℃
培養(yǎng)時(shí)間:24-48h
需氧類型:專性厭氧
分離基物:棉樹
采集地:**
保存方法: 冷凍干燥管保藏